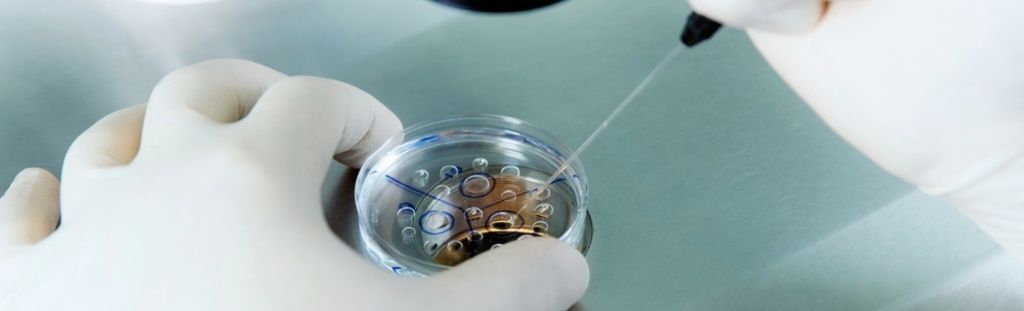
6 неделя беременности

Как растет животик
На 6-м месяце кожа на животе растягивается и может начать зудеть. Вдобавок к этому по мере развития беременности растет и вероятность появления растяжек на животе, груди и бедрах.
Физические упражнения, специальный бюстгальтер для беременных, бандаж, поддерживающий живот снизу, и увлажняющее средство (а лучше — специальный крем от растяжек для беременных) могут несколько снизить вероятность или выраженность этого явления. В период ожидания малыша растяжки иногда имеют более темный по сравнению с кожей на соседних участках цвет. После родов они начнут светлеть и со временем будут отличаться по цвету от более темной не затронутой ими кожи.
Во втором и особенно в третьем триместрах вас может беспокоить боль внизу живота. Мышцы брюшного пресса и связки, поддерживающие растущую матку, растягиваются и расходятся по мере ее роста. Это не может не вызывать ощущений, колеблющихся от покалывания до тянущих болей по бокам живота. Они могут возникать и усиливаться при смене положения тела, резких движениях и физических нагрузках. При таких болях хорошо помогает смена позы, переключение на другой вид деятельности, отдых и теплая ванна.
Хотя так бывает и не у всех женщин, вы также можете заметить необычные ощущения внизу живота, когда он на несколько секунд становится «каменным». Это ложные схватки, или тренировочные схватки Брэкстона-Хикса, — нерегулярные сокращения мышц матки и шейки матки, готовящейся к родам
Спазмы могут наблюдаться до 4 раз в час и длятся от 15 до 30 секунд, однако у некоторых мам они бывают и более продолжительными — до 2 минут.
Важно помнить, что тренировочные схватки не должны быть болезненными, хотя — и это зависит от болевой восприимчивости женщины — могут доставлять определенный дискомфорт. Другое важное отличие ложных схваток от родовых — отсутствие динамики в частоте и длительности сокращения мышц.
При схватках Брэкстона-Хикса врачи рекомендуют принять сидячее положение, положить ноги на возвышение и выпить стакан воды
Подобные рекомендации связаны с тем, что, по наблюдениям, тренировочные схватки усиливаются у мам, ведущих очень подвижный образ жизни, а также у тех, чей организм испытывает легкое обезвоживание.
Шестая неделя беременности: что нужно обсудить с врачом
Your prenatal visits are usually scheduled about once a month until the last two months of your pregnancy, when they will become more frequent. Прием у гинеколога — отличная возможность задать вопросы и поделиться опасениями.
Узнайте, какие физические упражнения разрешается делать во время беременности.
Где вы будете рожать и что нужно заранее знать о роддоме и его распорядках?
Если у вас хроническое заболевание (например, диабет или гипертония), проконсультируйтесь с врачом, как правильно продолжить лечение во время беременности и не поставить под угрозу безопасность малыша.
Нужно ли вам принимать фолиевую кислоту? И в каких дозировках?
Как будет проходить ведение беременности?
Если вы страдаете от тошноты, уточните у врача, считается ли ваш случай нормой или приступы слишком сильные. Некоторые будущие мамы сталкиваются с более серьезной формой тошноты, которая называется гиперемезис беременных.
Что происходит с малышом
Если попасть на УЗИ сейчас, можно услышать биение маленького сердечка. Частота сокращений 110-130 в минуту!
Сердечко крохотное, да и бьется так часто, что стетоскопом не прослушивается, а на УЗИ сердцебиение отображается в виде пульсирующей точке.
Каждый день зародыш меняется. Внешне эти изменения не видны, но внутри крохотного организма происходит настоящее чудо:
- оформляются глазные впадины, что позволяет дифференцировать лицо;
- закладывается наружное ухо и глазные яблоки;
- образуется головной мозг, в котором выделяются отделы (гипофиз, мост, мозжечок);
- формируются легкие, поджелудочная железа;
- оформляются гендерные различия, у мальчиков появляются яички, у девочек — яичники;
- обосабливается спинной мозг;
- укрупняются зачатки верхних и нижних конечностей.
Внешне эмбрион похож на маленького головастика или запятую. У него даже есть хвостик, который исчезнет к 8-9 неделе.
Какие изменения происходят в женском организме на 7-м месяце
1. Грудь. Молочные железы значительно увеличились в размере, стали тяжелее, в них продолжают формироваться молочные протоки, чтобы малыш после рождения получал свою первую «еду». Иногда у вас может выделяться молозиво — желтоватая жидкость, которая предшествует молоку и несет в себе бесценный запас иммуноглобулинов.
2. Кровообращение. Объем циркулирующей в вашем организме крови вырос на 30 – 50 %. Природа задумала это, чтобы обеспечить кровоснабжение для вас и вашего ребенка и компенсировать естественные кровопотери в родах.
3. Давление. Начиная с 30-й недели артериальное давление, после того как оно несколько понизилось в первом триместре, постепенно возвращается к физиологической норме.
4. Шевеления и другие сигналы изнутри. Многих женщин интересует, как часто они должны ощущать шевеления плода. Возможно, врач попросит вас подсчитывать их. Общий уровень активности индивидуален, как и количество шевелений, которое каждый малыш демонстрирует своей маме. Нет смысла сравнивать свою беременность с беременностями других мам — сравнивайте уровень активности своего малыша день ото дня.
Вероятнее всего, вы уже заметили, что у ребенка в вашем животе есть собственные внутренние часы. Подмечайте, сколько движений он делает в периоды своего бодрствования. Движения могут быть любые: пинки ногами, толчки локтями, кувырки или плавные помахивания ручками. Если вы замечаете серьезные различия в уровне активности малыша, обсудите это с вашим врачом.
5. Дыхание. Матка растет и оказывает давление на печень, желудок, кишечник и диафрагму, именно поэтому вы начали замечать, что вам становится немного труднее дышать. Весь текущий и следующий месяц это ощущение будет только усиливаться, а вот на 9-м месяце настанет облегчение: малыш опустится немного ниже в таз, это позволит вашим легким несколько «раскрыться», а вам — задышать «полной грудью».
6. Схватки Брэкстона-Хикса (тренировочные спазмы внизу живота) становятся интенсивнее. Теперь они длятся уже от 30 – 60 секунд до 2 минут и могут возникать от одного раза в несколько дней до нескольких раз в сутки.
7. Настроение. Поскольку внешние признаки вашей беременности очевидны для окружающих, вы становитесь объектом внимания: люди на улице и в общественных местах стараются вам помочь, уступают место, близкие и друзья трогают ваш животик. А вот на работе вас могут перестать воспринимать всерьез. Не сдавайте своих позиций, но и не переутомляйтесь.
Повышенное внимание накладывает отпечаток на психологическое состояние. Вы можете чувствовать раздражение, перепады настроения и испытывать желание, чтобы все побыстрее благополучно разрешилось
Это абсолютно нормально. Ищите позитивный выход своим негативным чувствам и мыслям. Например, если вы беспокоитесь, успеете ли купить все, что нужно для родов и ухода за младенцем, начните присматривать необходимые предметы уже сейчас.
8. Усталость. Вы можете чувствовать себя более усталой, чем прежде. Это происходит из-за растущего веса и изменения положения органов в животе. Вам хочется начать замедлять ваш ритм жизни, однако даже на это нужны силы.
Вот что может помочь:
- выполняйте короткие комплексы упражнений, которые могут вас взбодрить. На работе можно сделать несколько кругов вокруг здания или квартала, если вы дома — сходите в бассейн или на йогу для беременных;
- делайте короткие перерывы во время работы. Поднимите ноги и положите их на устойчивую поверхность, закройте глаза и отдохните, если свой рабочий день вы проводите в ходьбе или стоя. Если же у вас сидячая работа, вам нужны 5-минутные прогулки по офису каждый час, чтобы восстановить нормальное кровообращение;
- ешьте часто и маленькими порциями. Вам нужны сложные углеводы (зерновые) и хорошие протеины (постное мясо, морская рыба, яйца). Для перекусов подойдут фрукты, орехи и сухофрукты.
Что делать мужу во время беременности жены?
Проявлять интерес ко всему, что происходит. Если вы хотите быть в курсе всех событий, не игнорируйте свою жену, её беременность и проявления этой беременности, ведь в организме беременной женщины происходят изменения, которые, поистине, колоссальны. Вы увидите, как растёт её животик, чаще гладьте его, ласкайте жену, разговаривайте с животиком, как бы странно это не выглядело со стороны. Но ничего странного в этом нет, поверьте. И вашей жене будет очень приятно такое проявление ваших чувств.
Сопровождайте жену на медицинские осмотры и консультации. По мере возможности, постарайтесь посетить хотя бы некоторые из многочисленных посещений врача во время беременности и побывайте на обследованиях, которые предстоит пройти вашей беременной жене, хотя бы на самых важных из них. Во время обследований не стесняйтесь, спрашивайте у врача, интересуйтесь процессом протекания беременности, состоянием мамы и малыша и задавайте вопросы обо всех других моментах, которые вас интересуют.
Постарайтесь побывать на всех УЗИ во время беременности, чтобы не пропустить такого увлекательного зрелища, как ваш ребёнок на мониторе компьютера. Само собой, посещайте с женой курсы психологической подготовки к родам, если она записалась на них, чтобы быть готовым к разным ситуациям. Для будущего папы это хорошо по двум причинам: во-первых, вы не только сможете помочь вашей жене и поддержать её, но и, во-вторых, владея информацией обо всём, что происходит или будет происходить, вы сами будете меньше волноваться по этому поводу.
Не забывайте и о собственном здоровье. Наверняка, вы заметили, что ваша жена стала строже следить за своим питанием во время беременности и исключила все вредные привычки из своей жизни. Хорошим вариантом будет поддержать её в этом начинании, исключив вредные привычки и у себя и перейдя на здоровую пищу. Первое, от чего стоит избавиться — это курение и употреблние алкоголя. Или хотя бы уменьшить употребление алкоголя до минимума и употреблять его по особым случаям. Необходимо сделать это не только потому, что этим вы провоцируете жену к этому, но и потому, что пассивное курение может навредить вашему малышу. Больше времени уделяйте прогулкам и займитесь физическими упражнениями, например, в тот момент, когда ваша жена выполняет упражнения для беременных.
Любите вашу беременную жену. Любите её новое тело, её изменившиеся объёмы и формы. Поинтересуйтесь у вашей жены, хотела бы она, чтобы вы фотографировали её каждый месяц и оставляли на память все этапы её беременности? Стоит знать, что многие женщины, чувствуя свою неловкость и неуклюжесть из-за растущего живота, считают себя некрасивыми и непривлекательными в этот момент. Но для любящего мужа жена будет привлекательна на любом этапе беременности, и он обязательно будет говорить об этом свое женщине.
Если ваши интимные отношения в семье сейчас переживают спад, то проявите терпение. Колоссальные изменения на гормональном фоне и вытекающие из этого усталость, боли в спине во время беременности и просто переживания о предстоящих переменах, всё это способствует снижению либидо у вашей женщины. Мужчине стоит переждать этот период, ведь он обязательно закончится, а во время него поддерживать жену и не допускать охлаждения чувств к ней. В этот момент ей, как никогда, нужна ваша поддержка и ваши проявления чувств: ласки, нежные слова, объятья и поцелуи.
Возьмите на себя часть обязанностей жены. В период беременности ваша жена может стать капризной и часто даже невыносимой, но это нормальное явление, учитывая её нестабильный гормональный фон. Ей тоже нелегко, но, в отличии от вас, она не может ничего с собой поделать, все эти и другие изменения происходят из-за её беременности, независимо от того, хочет она этого, или нет.
Хорошим вариантом будет взять на себя часть семейных обязанностей, которые обычно выполняла жена. Например, ходите в магазины, убираться в квартире, готовить кушать, когда она не в состоянии, или активно помогать ей в этом. Чаще дарите жене цветы и принесите ей ночью в постель сладкий творог с чесноком, если она этого захочет и улыбнитесь.
Выделения на 6 неделе беременности
В первом триместре происходит изменение выделяемого количества различных гормонов. Это приходится на срок 4-6 недель беременности. При несбалансированной выработке гормонов выделения появляются несколько месяцев подряд в то время, когда должна быть менструация. Во время изменения гормонального фона, на этом сроке, коричневые выделения не являются угрозой жизни эмбриона.
Коричневые выделения проявляются в этот момент потому, что организм не приспособился к новому состоянию. Просто молодой маме следует правильно питаться, уменьшить физические нагрузки и не нервничать. Во время беременности выделения могут увеличиваться в количестве, и это тоже нормально. Однако, если коричневые выделения сопровождаются схваткообразными болями внизу живота и болями в пояснице, необходимо обратиться к врачу! Этому явлению есть несколько причин, которые могут негативно сказаться на формировании и развитии малыша.
Следующая причина, по которой женщина может наблюдать у себя темно-коричневые выделения на 6 неделе беременности — это вероятность отслойки плаценты. Это опасно тем, что возможна гибель плода. Ведь плацента — это орган, который связывает маму и плод, обеспечивая его жизнедеятельность. Физиологически отслойка этого органа представляет собой его полное или частичное отделение от оболочки матки. Когда это происходит, между плацентой и маткой скапливается кровь. За счет этого процесс отслойки усугубляется. Для того чтобы предотвратить отслойку плаценты, будущей маме следует избавиться от вредных привычек, больше гулять на свежем воздухе и сбалансированно питаться. В случае симптомов такого патологического процесса следует немедленно обратиться к гинекологу.
Третьей причиной кровянистых или коричневых выделений является — внематочная беременность. Кровянистые выделения на ранних сроках также свидетельствуют о возможной внематочной беременности. Это опасное состояние для самой женщины. Плодное яйцо растет в органе, не предназначенном для вынашивания и развития крохи, поэтому он просто лопается с течением времени.
Если беременность 6 недель, коричневые выделения появились, постоянно мучают боли внизу живота, ухудшается общее состояние, необходимо сразу обратиться к врачу. При таких симптомах часто назначается УЗИ. При наличии беременности в матке причины такого состояния дополнительно выясняются. Если диагностирована внематочная беременность, ее необходимо устранить.
Еще одной причиной возникновения темных выделений является наличие эрозии шейки матки. Когда у женщины беременность 6 недель, коричневые выделения могут быть спровоцированы этой болезнью. Если растревожить шейку матки, например, после осмотра в гинекологии или половой близости, появляется мазня.
В этом случае женщине необходимо удостовериться, что коричневые выделения на этом сроке беременности действительно спровоцированы эрозией. Если это так, то такое явление не представляет угрозы ребенку и маме. Но нельзя забывать об этом диагнозе, через некоторое время после родов необходимо вылечить поврежденную поверхность слизистой шейки матки.
В любом случае, появление кровянистых, коричневых и других тревожных выделений при беременности не должно остаться незаметным, обязательно обратитесь к врачу, чтобы выяснить причину выделений.
Некоторые напитки и их действие на организм
Тем не менее нужно понимать какие последствия могут быть от включения в рацион беременной женщины некоторых видов продуктов и напитков.
Что нужно знать о напитках: сладкая газированная вода может вызвать изжогу и не забывайте посмотреть на этикетку, какое содержание в ней красителей, усилителей вкуса и прочих вредных добавок. Если возникло жгучее желание, то лучше выбрать бесцветную сладкую воду. Щелочная минеральная вода в больших количествах может привести к накоплению в организме солей, поэтому такую воду рекомендуется пить не больше 10 дней, затем делать перерыв.
Алкогольные напитки вовсе не полезны, если ощущается острая необходимость то это может быть пол бокала- бокал красного вина максимум за весь период беременности. Такой напиток как кофе оказывает противоречивое действие: с одной стороны поднимая давление он создает нежелательные риски для малыша, а с другой — у многих беременных наблюдается пониженное давление по утрам. По поводу кофе и алкоголя лучше проконсультироваться у врача.
Подготовка к процедуре ЭКО
- Отказаться от вредных привычек. Курение, употребление алкоголя и психоактивных препаратов негативно влияет на весь организм. В том числе на репродуктивную систему. В сигаретах, спиртных напитках, наркотиках содержится целый комплекс веществ, вызывающих клеточные мутации, интоксикацию и иные негативные последствия для здоровья. Даже в небольших дозах они способны нанести вред репродуктивной системе и снизить вероятность успешного зачатия. Более того, у женщин вредные привычки вызывают патологии, которые даже после наступления беременности провоцируют аномалии плода или делают невозможным вынашивание и рождение ребенка.
- Проверить вес тела. Недостаточная или избыточная масса нарушают нормальную работу как мужской, так и женской репродуктивной системы, отрицательно сказываются на качестве половых клеток. Для успешного оплодотворения необходимо контролировать индекс массы тела. Высчитать его можно, разделив вес (в кг) на квадрат роста (в м2) – допустимый интервал составляет 19-30 кг/м2. При выходе за пределы этих значений ЭКО лучше перенести до тех пор, пока индекс массы тела не вернется к нормальным значениям. Также необходимо пройти медобследование, чтобы выявить возможные эндокринные, психические и другие патологии, спровоцировавшие проблемы с весом.
- Придерживаться принципов здорового питания. Для успешного зачатия оба родителя должны получать весь комплекс питательных веществ – белки, жиры, витамины, углеводы, жирные кислоты и т. д. Поэтому перед ЭКО противопоказано соблюдение строгих и монодиет, употребление продуктов с большим количеством пищевых добавок, заменителей, растительных трансжиров. Рекомендуется включить в рацион свежие овощи и фрукты, морскую рыбу, запеченное или приготовленное на пару нежирное мясо (курицу, говядину), кисломолочные продукты.
- Принимать витаминно-минеральные комплексы. В период беременности и вынашивания плода женскому организму необходимы такие витамины, как В6 и В12, фолиевая кислота – без них возрастает вероятность развития детских патологий у плода. Также полезно увеличить потребление кальция, цинка, магния, фосфора, железа и других минералов. Точную дозировку должен назначить врач-диетолог, так как гипервитаминоз также может быть опасен для матери и ее ребенка, как и недостаток биологически-активных веществ.
- Вести активный образ жизни. Обоим будущим родителям рекомендуется увеличить физическую активность – это укрепляет организм и помогает справиться со стрессом. Однако, для женщины в период проведения ЭКО противопоказаны большие нагрузки, поэтому лучше выполнять легкие упражнения по 30-40 минут в день 3-4 раза в неделю. Хорошо подойдет легкий бег, пилатес, йога или простая прогулка на свежем воздухе.
- Сделать прививки. Некоторые бактериальные и вирусные инфекции (герпес, грипп, краснуха и т. д.) в пренатальный период способны вызвать генетические отклонения у плода. Перед ЭКО женщине необходимо пройти обследования на эти заболевания и, при отсутствии иммунитета к ним, сделать прививки. Также, при наличии хронических заболеваний, рекомендуется проконсультироваться с врачом, чтобы он скорректировал курс лечения и предложил наиболее оптимальный протокол ЭКО с учетом всех рисков для матери и ребенка.
- Ограничить сексуальную активность. Подготовка к ЭКО не оказывает значительного влияния на половую жизнь будущих родителей. Однако, им обоим стоит отказаться от всякой сексуальной активности за 3-4 дня до пункции фолликулов и в течение 7 дней после экстракорпорального оплодотворения. Это необходимо для получения достаточного количества спермы у мужчин и повышения вероятности успешного закрепления эмбриона в матке.
Полный перечень всех рекомендаций индивидуален и зависит от возраста будущих родителей, состояния их здоровья и многих других факторов. Поэтому перед процедурой ЭКО им обоим нужно проконсультироваться с врачом – только он может назначить все необходимые меры, повышающие шансы на успешное наступление беременности.
Ощущения женщины. 3 недели после ЭКО
Спустя 3 недели после экстракорпорального оплодотворения, будущая мама может столкнуться с основными признаками беременности, сопровождающими изменения в организме. Наиболее часто женщины отмечают:
Утреннюю тошноту. Ранний токсикоз является наиболее характерным симптомом беременности, особенно для женщин, принимающих поддерживающие препараты;
Изменения настроения. Меняющийся гормональный фон приводит к эмоциональной лабильности большинства беременных женщин
Обострение нервных реакций является естественным процессом, но женщинам после ЭКО особенно важно избегать негативных эмоций;
Чувствительность груди. Обострение чувствительности грудных желез и увеличение их объема – один из первых признаков любой беременности
Перемены в структуре молочных желез начинаются с первого дня зачатия и именно разрастание железистой ткани приводит к возрастанию чувствительности и некоторой болезненности при прикосновениях.
Кроме основных трех признаков, сопровождающих большинство беременностей, существуют и другие, носящие индивидуальных характер, например: сонливость, повышение утомляемости, тяжесть внизу живота, обострение обоняния и др.
Беременность: с чего все начинается
Длится беременность 40 недель, или 280 суток, с первого дня последней менструации. У большинства женщин менструальный цикл составляет 28 дней. Однако границы нормы простираются от 21 до 35 дней у взрослых женщин.
Между 11-м и 21-м днями каждого менструального цикла в женском организме идет процесс овуляции, который потенциально может привести к беременности. В период овуляции яйцеклетка, выделяемая яичником, движется по фаллопиевой трубе в направлении матки. В это же время эндометрий (слизистая поверхность) матки готовится к тому, чтобы принять и поддержать будущую беременность: он утолщается, растет его кровоснабжение.
В такой готовности матка будет пребывать еще около 14 дней. Если яйцеклетка не встретилась со сперматозоидом, она в одиночестве продолжает свой путь к матке. В отсутствие оплодотворенного яйца матка избавляется от лишнего слоя эндометрия вместе с яйцеклеткой, и начинается менструация.
Если яйцеклетка и сперматозоид встречаются и сливаются, наступает беременность.
Несмотря на то, что яйцеклетка уже оплодотворена, пройдет еще несколько дней, прежде чем домашний тест на беременность сможет показать положительный результат. Это зависит от гормона ХГЧ (хорионический гонадотропин человека), вырабатываемого плодным яйцом.
Гормон ХГЧ сообщает яичнику, что оплодотворение совершилось, и поддерживает приток крови к слизистой оболочке матки, чтобы плодное яйцо продолжало свое развитие.
Наличие в моче или крови гормона ХГЧ прямо свидетельствует о том, что беременность началась. Подтвердить это на самой начальной стадии могут анализы мочи (домашний тест на беременность) и крови (из вены, лабораторный).
После установления факта беременности и вам самим, и уж тем более вашему доктору необходимо установить ее срок. Как это делается?








Какая замечательная новость! На 6 неделе уже можно начинать чувствовать первые изменения, главное — заботиться о себе и прислушиваться к своему телу. Все будет хорошо!